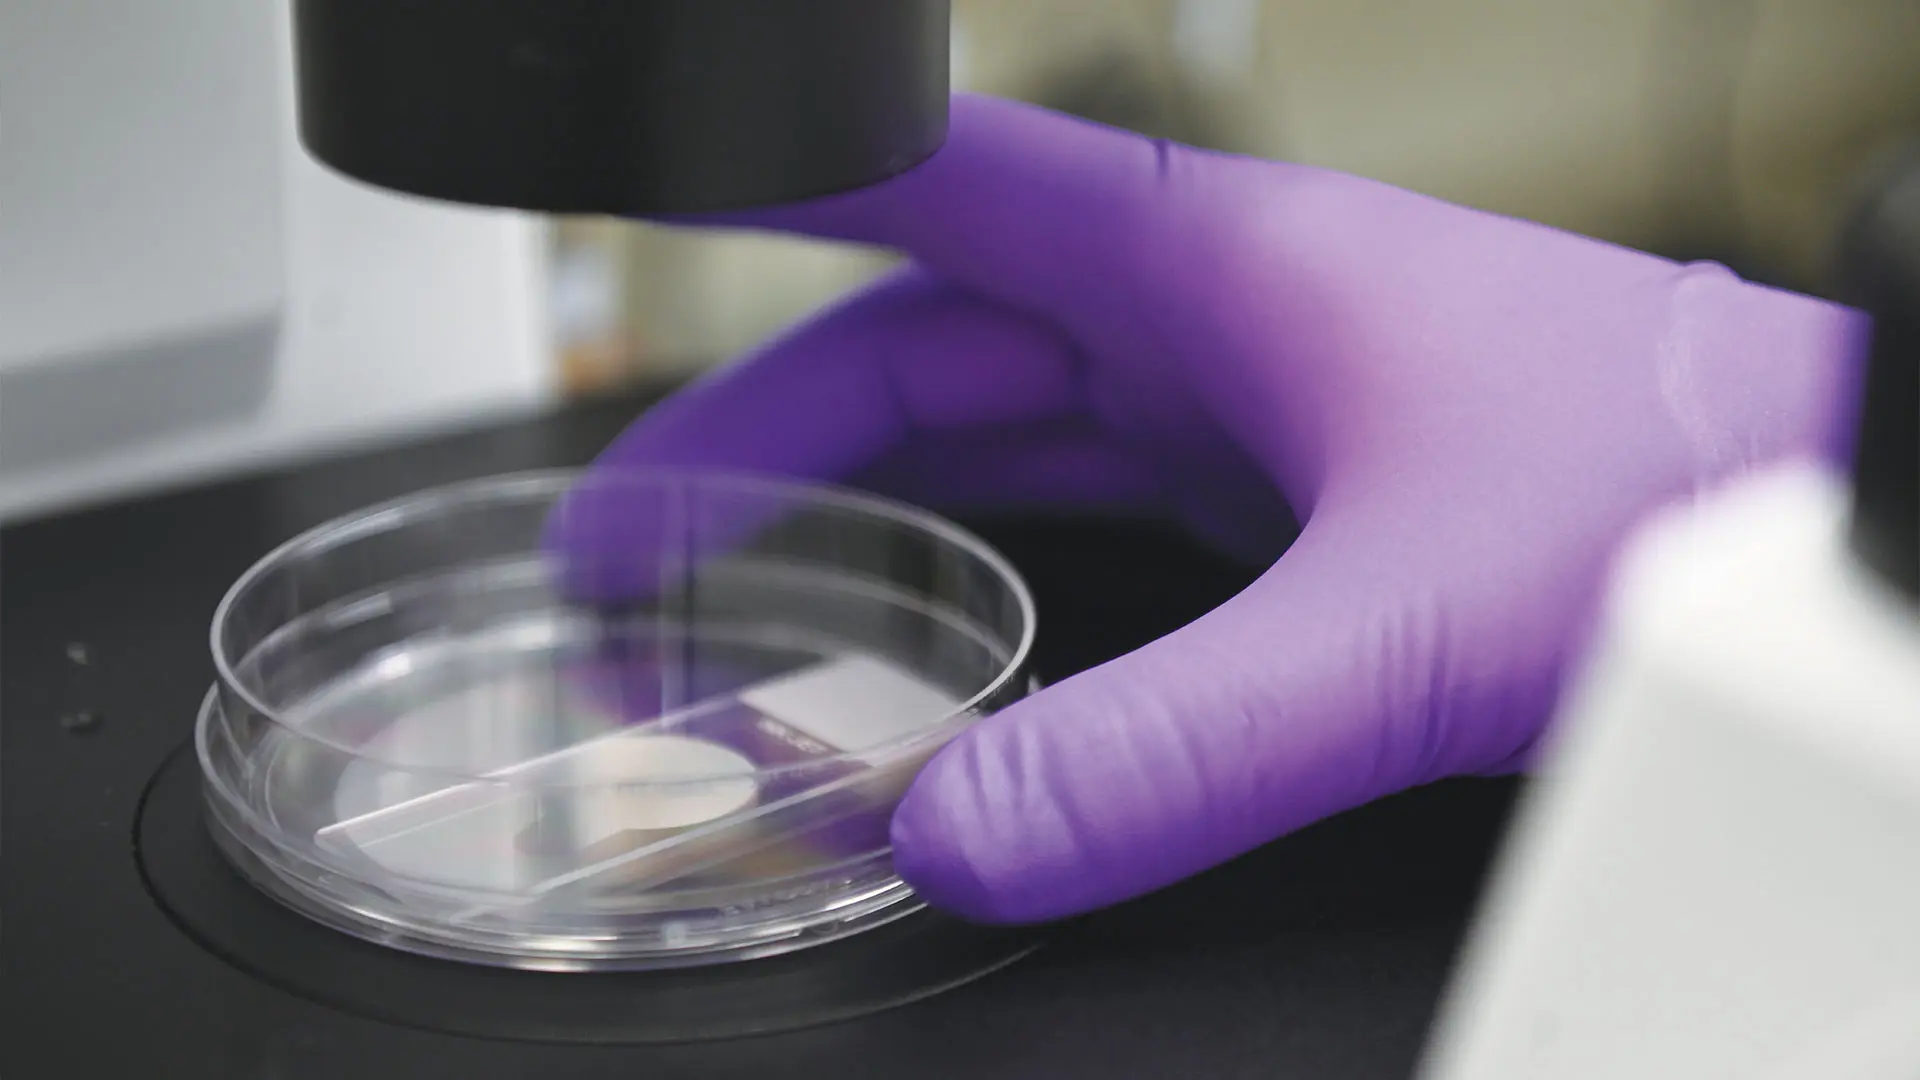

As leaders and visionaries, the members of the Dermatology Advisory Board generously lend their expertise, energy, and philanthropic resources to support the endeavors of the Kimberly and Eric J. Waldman Department of Dermatology under the leadership of Emma Guttman-Yassky, MD, PhD, System Chair and Waldman Professor of Dermatology at the Icahn School of Medicine at Mount Sinai. The transformational impact of the Board’s contributions, through championing innovative research and fostering medical breakthroughs, ultimately benefits not only our patients but millions of patients all over the world.
The Board recognizes the mission of the Department to deliver exceptional, comprehensive patient care and advance the science of dermatology through research and education. The Department has the unique ability to conduct therapeutic and translational research, quickly bringing discoveries made in the laboratory to clinical trials and then directly to patients. This mission would simply not be possible without the Dermatology Advisory Board.
At the Department of Dermatology, we are proud of our more than 40-year record of clinical and research achievements and look forward to continued partnership with the Board. With the Board’s steadfast support and philanthropic commitment, we strive to push the boundaries of research and clinical care, and build a brighter, healthier future for our patients and their families.
Members of the Dermatology Advisory Board
Frances Bivens
Andrew Bronin, MD
Robert Buka, MD
Elissa Cullman
Robert and Nancy Davis
Shoshana Dichter
Yuri Frayman
David Granson
Mehdi and Olga Khosrow-Pour
Leon Kircik, MD
Herbert Kozlov
Michael Lee
Jody A. Levine, MD, and Elie Levine, MD
Eyal K. Levit, MD
Michael Mandelbaum
Will Manuel
Marybeth Marcus
Amanda Mullen
Catherine Orentreich, MD
David Orentreich, MD
Jonathan Pure
Nina Reeves
Ada Samuelsson
Allen Sapadin, MD
Steven Schnur and Eliane Braz-Schnur
Eric Schweiger, MD
Kimberly and Eric J. Waldman
Huachen Wei, MD, PhD
John Weinberg
Johannes Worsoe
Carol F. Zale, MD, and David Zale
Honorary Board Member/Scientific Advisor:
George Yancopoulos, MD, PhD